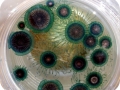
Blue Button Jelly

“Porpita porpita”
Although it has ‘jelly’ in its name, the Blue Button Jelly is not a Sea Jelly. It is a hydroid – an animal in the class Hydrozoa, which are colonial animals. The Blue Button Jelly is made up of individual zooids, each specialized for a different function such as eating, defense or reproduction. The Blue Button Jelly is related to sea jellies and belongs to the Phylum Cnidaria, the group of animals that also include corals, sea jellies, sea anemones and sea pens. The Blue Button Jelly is relatively small and measure about 1 inch in diameter. They consist of a hard golden-brown, gas-filled float in the center, surrounded by blue, purple or yellow hydroids which look like tentacles. The tentacles have stinging cells called nematocysts. Blue Button Jellies are found in warm waters off Europe, in the Gulf of Mexico, Mediterranean Sea, New Zealand and in southern U.S. waters. These hydroids live on the ocean surface, are sometimes blown in to shore and sometimes seen by the thousands. Blue Button Jellies eat plankton and other small organisms. The Blue Button itself is a passive drifter and is part of the neustonic food web. It is preyed on by the Sea Slug & Sea Snails. It competes with other drifters for food and mainly feeds on copepods and crustacean larvae. They are hermaphrodites – each Blue Button Jelly has both male & female sex organs. They have reproductive polyps that release eggs & sperm into the water. The eggs are fertilized and turn into larvae, which then turn into individual polyps.
Blue Button Jellies are actually colonies of different types of polyps – these colonies form when a polyp divides to form new types of polyps. The polyps are specialized for different functions such as reproduction, feeding & defense. It’s best to avoid these beautiful organisms if you see them – Blue Button Jellies do not have a lethal sting, but they can cause skin irritation when touched. Blue Buttons live on the surface and are not real sea jellies but are Chondrophores. Chondrophores are colonies of polyps. Each polyp contributes something different to the colony. The float is the first of the 2 main parts of the Blue Button Jelly. It is a round disc like shape and is a golden-brown color. It is usually about 1.5 inches wide or less and has a single mouth underneath the float which is used for both the intake of nutrients & dispersal wastes. The hydroid colony (sea jelly-like tentacles) are bright blue, turquoise or yellow. They have gaseous bodies which allow them to float on the surface and are propelled by wind & ocean currents. This causes them to frequently be washed on to beaches. Blue Button Jellies are hermaphrodites (i.e. both male & female). The specialized reproductive polyps release both eggs & sperm into the water. When the eggs have been fertilized by the sperm, they develop into larvae that subsequently metamorphose into individual polyps. A Blue Button Jelly colony forms when one polyp divides to form new types of polyps which become specialized for different functions.